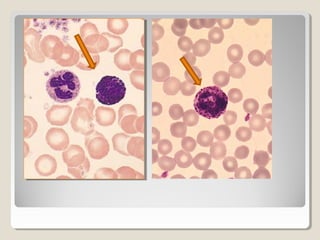
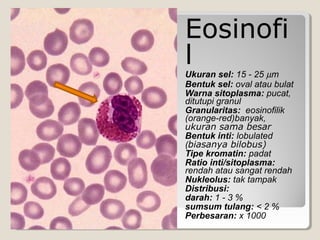
Eosinofi
l
Ukuran sel: 15 - 25 µm
Bentuk sel: oval atau bulat
Warna sitoplasma: pucat,
ditutupi granul
Granularitas: eosinofilik
(orange-red)banyak,
ukuran sama besar
Bentuk inti: lobulated
(biasanya bilobus)
Tipe kromatin: padat
Ratio inti/sitoplasma:
rendah atau sangat rendah
Nukleolus: tak tampak
Distribusi:
darah: 1 - 3 %
sumsum tulang: < 2 %
Perbesaran: x 1000
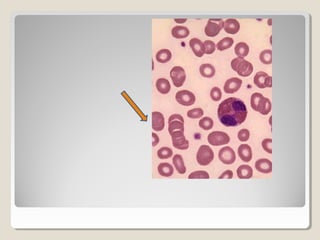
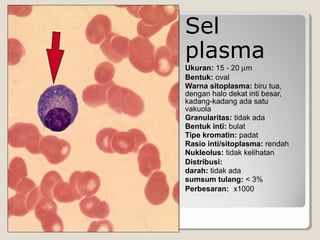
Sel
plasma
Ukuran: 15 - 20 µm
Bentuk: oval
Warna sitoplasma: biru tua,
dengan halo dekat inti besar,
kadang-kadang ada satu
vakuola
Granularitas: tidak ada
Bentuk inti: bulat
Tipe kromatin: padat
Rasio inti/sitoplasma: rendah
Nukleolus: tidak kelihatan
Distribusi:
darah: tidak ada
sumsum tulang: < 3%
Perbesaran: x1000

Dokumen tersebut membahas tentang leukosit dan prosedur hitung jenis leukosit. Terdapat 6 jenis utama leukosit yaitu basofil, eosinofil, neutrofil batang, neutrofil segmen, limfosit, dan monosit. Prosedur hitung jenis leukosit meliputi pengambilan contoh darah, pemeriksaan di bawah mikroskop, dan pengelompokkan 100 sel leukosit berdasarkan jenisnya.